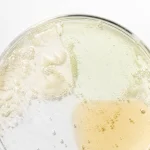
Beauty of Joseon - Hanbang Serum Discovery Kit - Set of 4 Serums in Miniature Version - 4x10ml

Co sada obsahuje?
Sada Beauty of Joseon – Hanbang Serum Discovery Kit obsahuje čtyři různorodá séra, každé v praktickém 10 ml balení, ideálním na cestování. Obsahuje:
- Green Tea Calming Serum – pro zklidnění pleti
- Glow Serum Propolis and Niacinamide – pro rozjasnění pleti
- Glow Deep Serum Rice and Alpha-Arbutin – pro zlepšení tónu pleti
- Ginseng Revive Serum – pro revitalizaci a posílení pleti
Tato séra jsou navržena tak, aby pokryla široké spektrum potřeb pleti a umožnila vám vyzkoušet jejich účinky.
Jaké jsou hlavní účinky každého séra?
Každé sérum v sadě přináší specifické benefity pro pleť:
- Green Tea Calming Serum: Ideální pro citlivou pleť, zklidňuje podráždění a podporuje regeneraci díky hydrolátu z listů zeleného čaje a extraktu z pupečníku asijského.
- Glow Serum Propolis and Niacinamide: Zaměřuje se na rozjasnění pleti, redukci pigmentových skvrn a zarudnutí. Propolis a niacinamid v jeho složení pomáhají čistit ucpané póry a regulovat nadměrnou produkci mazu.
- Glow Deep Serum Rice and Alpha-Arbutin: Sjednocuje tón pleti a redukuje pigmentaci. Obsahuje hydrolát z rýže a koncentrovaný alpha-arbutin pro efektivní zesvětlení skvrn.
- Ginseng Revive Serum: Revitalizuje a hydratuje pleť, navrací jí přirozený lesk a sjednocuje tón. Díky ženšenu a šnečímu extraktu podporuje regeneraci a zanechává pleť svěží.
Proč si vybrat Beauty of Joseon?
Beauty of Joseon je značkou, která efektivně spojuje tradiční korejské ingredience s moderními technologiemi péče o pleť. Proč zvolit Beauty of Joseon?
- Přirozené ingredience: Každé sérum je pečlivě formulováno s tradičními korejskými složkami.
- Adaptabilita: Produkty jsou navrženy tak, aby vyhovovaly specifickým potřebám různých typů pleti.
- Viditelné výsledky: Odborníci dbají na výběr kvalitních a účinných složek pro dosažení zdravé a zářivé pokožky.
- Flexibilita péče: Hanbang Serum Discovery Kit umožňuje přizpůsobit péči přesně podle potřeb vaší pleti, s důvěrou v osvědčené korejské receptury.

Získejte
Získejte 































Recenze
Zatím zde nejsou žádné recenze.